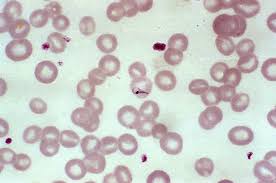

몸이 자주 피곤하고 어지럽다면 헤모글로빈 수치가 낮은 빈혈 증상일 가능성이 높습니다. 🩸 헤모글로빈은 우리 몸의 세포에 산소를 운반하는 단백질로, 부족하면 전신 피로와 두통, 집중력 저하가 생깁니다.
이번 글에서는 헤모글로빈 수치가 낮을 때의 증상, 원인, 개선법을 자세히 알아보겠습니다.
1. 헤모글로빈이란? 🧬
헤모글로빈은 적혈구 속에 존재하는 단백질로, 폐에서 산소를 받아 온몸으로 전달하고 이산화탄소를 다시 폐로 운반하는 역할을 합니다. 수치가 낮으면 체내 산소 공급이 부족해져 피로감, 어지럼, 창백한 피부 등 다양한 증상이 나타납니다.
2. 헤모글로빈 정상수치 📊
| 구분 | 정상 범위 (g/dL) |
| 성인 남성 | 13.0 ~ 17.0 |
| 성인 여성 | 12.0 ~ 15.0 |
| 임산부 | 11.0 이상 권장 |
3. 헤모글로빈 수치가 낮을 때 나타나는 증상 ⚠️
- 만성 피로와 무기력
- 얼굴 창백, 입술 색이 옅어짐
- 어지럼, 두통, 집중력 저하
- 손발 저림, 체온 저하
- 심장이 두근거리거나 숨이 참
- 손톱이 푸르거나 쉽게 부러짐
- 머리카락이 가늘어지고 빠짐
4. 헤모글로빈 수치가 낮은 원인 🔍
1) 철분 부족
가장 흔한 원인으로, 철분이 부족하면 적혈구 내 헤모글로빈 합성이 줄어듭니다. 특히 여성은 생리나 출산으로 철 손실이 많습니다.
2) 엽산·비타민B12 부족
이 영양소들은 적혈구 생성에 필수적입니다. 부족하면 빈혈뿐 아니라 신경 손상 증상도 동반될 수 있습니다.
3) 출혈
위궤양, 치질, 생리 과다, 소화기 출혈 등으로 혈액이 손실되면 헤모글로빈 수치가 급격히 낮아집니다.
4) 만성 질환
신부전, 갑상선 기능 저하, 간 질환, 암 등의 만성 질환은 적혈구 생성 억제를 일으켜 수치를 떨어뜨립니다.
5) 골수 질환
적혈구를 만드는 골수가 손상되면 정상적인 적혈구 생성이 어렵습니다. 재생불량성 빈혈, 백혈병 등이 해당됩니다.
콩팥이 안좋으면 나타나는 증상ㅣ원인ㅣ대처방법
콩팥은 신장이라고도 하며, 우리 몸의 노폐물과 독소를 걸러내는 중요한 기관입니다. 💧 하지만 콩팥 기능이 떨어지면 체내 균형이 무너지고 다양한 이상 증상이 나타납니다. 이번 글에서는 콩
ask.pebblesblog.co.kr
5. 헤모글로빈 수치 낮을 때의 개선 방법 💡
1) 철분 섭취 늘리기
쇠고기, 간, 시금치, 달걀노른자 등 철분이 풍부한 음식을 섭취하세요. 비타민C와 함께 먹으면 흡수율이 높아집니다.
2) 엽산·비타민B12 보충
엽산은 시금치, 브로콜리, 아스파라거스에 풍부하며, 비타민B12는 달걀, 연어, 유제품에서 섭취할 수 있습니다.
3) 규칙적인 식사와 수면
불규칙한 생활습관은 체내 대사를 저하시켜 적혈구 생성을 방해합니다. 일정한 식사 시간과 충분한 수면이 필요합니다.
4) 카페인 섭취 줄이기
커피, 홍차의 탄닌 성분은 철분 흡수를 방해하므로 식후 바로 마시지 않는 것이 좋습니다.
5) 운동하기
적당한 유산소 운동은 혈액순환을 개선하고, 적혈구 생성을 자극합니다. 걷기나 가벼운 조깅이 도움이 됩니다.
적혈구 수치가 높은 이유ㅣ원인ㅣ증상ㅣ해결방법
건강검진 결과에서 “적혈구 수치가 높다”는 말을 들으면 걱정이 되죠. 🩸 적혈구는 산소를 운반하는 중요한 혈액 성분이지만, 수치가 지나치게 높으면 혈액이 끈적해지고 혈관 질환 위험이
ask.pebblesblog.co.kr
6. 헤모글로빈을 높이는 음식 🥗
- 쇠고기, 간 – heme 철분 풍부
- 시금치, 브로콜리 – 엽산 공급
- 달걀, 연어 – 비타민B12 함유
- 건자두, 사과 – 철분 흡수 보조
- 비트 – 혈액 생성을 촉진
7. 요약표 📋
| 원인 | 증상 | 개선 방법 |
| 철분 부족 | 피로, 창백, 어지럼 | 쇠고기, 간, 비타민C 섭취 |
| 엽산 부족 | 집중력 저하, 피로 | 시금치, 브로콜리 |
| 비타민B12 부족 | 손발 저림, 빈혈 | 달걀, 연어, 유제품 |
| 만성질환 | 지속적 피로감 | 질환 치료 병행 |
8. 자주 묻는 질문 🙋
1) 철분 보충제는 언제 먹는 게 좋나요?
공복 또는 식사 1시간 전후에 비타민C와 함께 섭취하면 흡수율이 높습니다.
2) 헤모글로빈 수치가 낮으면 운동해도 될까요?
무리가 가지 않는 가벼운 운동은 도움이 되지만, 심한 빈혈이 있을 때는 휴식이 우선입니다.
3) 커피나 녹차가 헤모글로빈 수치에 영향을 주나요?
네. 탄닌 성분이 철분 흡수를 방해하므로 식후 1~2시간 후에 마시는 것이 좋습니다.
9. 결론 ✅
헤모글로빈 수치가 낮으면 피로와 어지럼이 반복되어 일상생활의 활력이 떨어집니다. 철분과 비타민 섭취, 규칙적인 생활습관을 통해 건강한 혈액 상태를 유지하세요.
이 글이 도움이 되셨다면 왼쪽 아래 공감(♥)버튼 눌러주시면 감사하겠습니다!

'건강' 카테고리의 다른 글
| 코피가 자주나는 이유ㅣ원인ㅣ대처법 (0) | 2025.11.15 |
|---|---|
| 비립종 생기는 이유ㅣ원인ㅣ해결방법 (0) | 2025.11.15 |
| 꼬리뼈가 아픈 이유ㅣ원인ㅣ치료법 (0) | 2025.11.14 |
| 왼쪽 갈비뼈 아래 통증ㅣ대처방법 (0) | 2025.11.14 |
| 발바닥이 화끈거리는 이유ㅣ대처방법 (0) | 2025.11.14 |